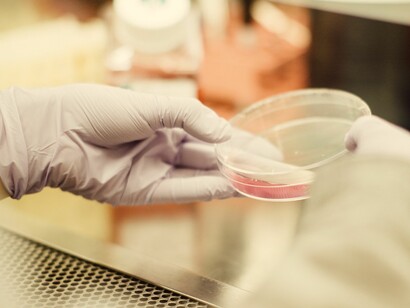
América Latina no puede perder el tren de la ciencia en pleno siglo XXI

Desde los tiempos de Benjamin Franklin ya se practica la diplomacia científica, desde luego siglos antes en Europa, Asia, el Medio Oriente y otras latitudes; entre las potencias como Inglaterra, Francia, Alemania, EEUU, Rusia, China o Japón, su existencia ha sido innegable. Hoy día este concepto pretende resurgir como reconocimiento a través del lenguaje científico, que expuesto por científicos a políticos y a la sociedad civil, toma relevancia y un mayor posicionamiento de esta práctica de los investigadores. En Iberoamérica, la cooperación española está compartiendo sus experiencias con algunas naciones latinoamericanas.
La Agencia Española para la Cooperación Internacional para el Desarrollo (AECID) ha propiciado el tema, llevando a cabo uno de los primeros cursos iberoamericanos. La Secretaría de Estado de Investigación y Desarrollo e Innovación (SEIDI) y la Fundación Española para la Ciencia y Tecnología (FECYT), bajo el Marco del Plan Interconecta, organizaron el curso sobre Diplomacia Científica para Gestores Públicos de América Latina en el Centro de Formación de (AECID) en Santa Cruz de la Sierra en Bolivia, del 11 al 14 de diciembre de 2017.
El Ministerio de Relaciones Exteriores y Cooperación (MAEC) de España, y la Escuela Diplomática Española, fueron a su vez garantes de la asistencia de alrededor de una treintena de diplomáticos, científicos- investigadores, gestores públicos y otros expertos de once países latinoamericanos y de los Estados Unidos con la presencia de participantes de los Departamentos de Estado y de Salud, así como de especialistas del Programa Regional de Políticas de Ciencia Tecnología e Innovación, de la Unesco, como también del Centro de Diplomacia Científica de la Academia Americana para el Avance de las Ciencias (AAA).
Las jornadas de trabajo para tratar el tema se aunaron bajo el esquema de cómo un mundo interconectado y de libre comercio demanda cada vez más de las relaciones internacionales y de las políticas en ciencia tecnología e innovación, para que las mismas sean insertadas en esta globalidad, dado que el conocimiento está cada vez más obligado a disponer de la evidencia científica para decisiones, por los mismos retos que hoy se nos presentan tales, como el cambio climático, las nuevas energías alternativas y la inmediatez cotidiana.
De la mesa redonda La Diplomacia Científica en la Región Iberoamericana y sus perspectivas se deduce que ha estado presente también desde hace mucho tiempo en América Latina. Algunos ejemplos serían: el Programa Iberoamericano de Ciencia y Tecnología para el Desarrollo (CYTED), que ha impulsado redes de especialistas en diversas temáticas, al igual que la Organización de Estados Iberoamericanos, (OEI), como los programas y objetivos del Sistema de Naciones Unidas, (2030) y los de la Unión Europea, (Horizonte 2020), de igual manera la Organización de Estados Americanos, (OEA), con la Comisión para el Desarrollo Científico y Tecnológico de Centroamérica y Panamá, la (CTCAP), también entidades financieras como el Banco Interamericano de Desarrollo, (BID), han propiciado intercambios del conocimiento científico, que involucran a los científicos, los políticos y a la sociedad civil directamente.
Se concluyó luego de análisis, deliberaciones y ejercicios con escenarios, como suele aplicarse en los estudios internacionales, coadyuvando a escenificar los desafíos científicos, políticos y económicos que enfrenta el siglo XXI, en un futuro inmediato retador, reflexionando con un llamado a todos los sectores participantes para apropiarse mejor del conocimiento y la información que las nuevas tendencias de la Sociedad del Conocimiento demandan hoy.
Como resultado fueron elaboradas una serie de recomendaciones para que los sectores participantes propicien en la sociedad como lenguaje universal, el intercambio científico para enfrentar con un conocimiento más certero los desafíos del cambio climático, las alternativas energéticas sostenibles, la ciberseguridad, los desastres naturales, la proliferación nuclear, las enfermedades emergentes y las pandemias, para que se cuenten con acuerdos diplomáticos científicamente respaldados y ojalá amparados a las Convenciones de Viena Sobre Relaciones Diplomáticas de 1964, y la del Derecho de Tratados de 1969. Algunas de estas recomendaciones se emiten esencialmente tanto para los gobiernos, los sectores académicos, científicos e industriales como para la sociedad civil. Visto por segmentos y responsabilidades de cada cual:
A los Gobiernos
A los gobiernos le toca reconocer el valor de la Investigación, Desarrollo e Innovación (I+D+I) como elemento clave de prosperidad de los países y a la generación de sociedades basadas en el conocimiento. Tomar decisiones políticas fundamentales mediante un asesoramiento científico experto, basadas en evidencias. Vincular científicos, políticos, gestores y sociedad en general para que el conocimiento científico enriquezca la gestión pública y se contribuya al ciclo completo de la investigación, dígase; (definición de problemáticas y prioridades, diseño, y explotación de resultados, evaluación). Facilitar movilidades, integraciones y colaborar con las Asociaciones de científicos nacionales, con el exterior abriendo espacios Iberoamericanos de (CT&I), propiciando la libre circulación del talento para una mayor colaboración científica.
Al Sector académico y científico
Fortalecer redes internacionales y nacionales de científicos y las academias nacionales de ciencia para proponer soluciones técnicas y científicas a problemas comunes en Latinoamérica y Caribe a políticos y responsables de decisiones políticas públicas. Incluir la disciplina de diplomacia científica en las políticas universitarias y los centros de investigación de manera que se fomente la investigación, docencia y extensión en este nuevo campo. Fortalecer y propiciar programas de contacto e intercambio entre los científicos y las autoridades políticas y diplomáticas.
Al Sector Industrial
Invertir de forma sostenible y razonable en I+D+I, considerando tanto aspectos de retorno financiero como de retorno social. Facilitar la incorporación de doctores y científicos en todos los niveles de gestión del tejido industrial del país. Fomentar alianzas de cooperación público-privada para el desarrollo de proyectos de Investigación, Desarrollo e Innovación.
A la Sociedad Civil
Reclamar la inclusión de la I+D+I como prioridad en la agenda de sus representantes (partidos políticos) desde lo local hasta lo global, llevando a la atención de la agenda política problemas sociales que requieran de una solución para el desarrollo científico y tecnológico (escasez de recursos naturales, potabilidad del agua, o en general los Objetivos del Desarrollo Sostenible enunciados por la (ONU).
Se plantean más recomendaciones que, sin duda alguna, serán objeto de análisis, así como otras más en nuevos eventos de esta índole en Iberoamericana y otras latitudes.